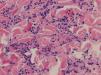

La anetodermia es una dermatosis rara, crónica y adquirida que cursa con pérdida de fibras elásticas, y para la que no existe tratamiento específico eficaz1,2. Se presenta una paciente con anetodermia primaria (AP) asociada a síndrome de Sjögren primario y anticuerpos anticardiolipina positivos, en cuya biopsia destaca un infiltrado inflamatorio agudo en la dermis reticular, y que fue tratada con colchicina y dapsona.
Se trata de una mujer de 21 años, con antecedentes de depresión y bulimia por la que recibía duloxetina, con buen control de su enfermedad de base, sin episodios recientes de cambio de peso. Acudió al Servicio de Dermatología en junio de 2009 por la aparición progresiva de pápulas de 5mm eritematosas y dolorosas, que evolucionaban a placas normocrómicas de aproximadamente 1×2cm, blandas al tacto, en la parte alta de los brazos y el tercio superior de la espalda (fig. 1). La paciente no refería episodios previos de abortos, infertilidad, ni trombosis vascular.
Venía remitida por Reumatología, donde había sido estudiada por xerostomía y xeroftalmia. Presentaba un test de Schirmer positivo (3mm a los 5 min en el ojo derecho y 5mm en el izquierdo), y una disminución de la secreción salival medida por sialografía (0,3ml basal y 6,1ml postestimulación). Analíticamente destacaban ANA patrón moteado de 1/320, positividad para antiRo/SS-A y antiLa/SS-B, factor reumatoide 56 UI/ml (VN<20), C4 8,66mg/100ml (VN: 12-36) y anticuerpos anticardiolipina IgM 6,73 MPL/ml (VN<4,6). La serología para VIH, los anticuerpos anti-beta-2-glucoproteína i y el anticoagulante lúpico fueron negativos. Dados estos hallazgos fue diagnosticada de un síndrome de Sjögren primario por el Servicio de Reumatología, sin cumplir criterios para síndrome antifosfolípido ni para lupus eritematoso.
Se realizó una biopsia de las lesiones cutáneas que mostró en la dermis reticular un infiltrado inflamatorio perivascular e intersticial compuesto por linfocitos e histiocitos con abundantes neutrófilos y eosinófilos (fig. 2). La tinción para fibras elásticas mostró fragmentación y desaparición de estas fibras en la dermis papilar y reticular (fig. 3). Con estos hallazgos se diagnosticó de AP en una paciente con un síndrome de Sjögren primario.
Se inició tratamiento con colchicina 1,5mg/d con estabilización de las lesiones, pero se suspendió a los 2 meses por intolerancia digestiva. Ante la aparición de nuevas lesiones eritematosas dolorosas se inició dapsona 50mg/d con buena tolerancia, aumentándose hasta 100mg/d, con mejoría de los síntomas y estabilización del cuadro. En diciembre de 2011 el tratamiento se suspendió por parestesias al nivel de las manos. Se realizó electromiograma que fue compatible con un síndrome del túnel carpiano, descartándose así una neuropatía por dapsona. Dado que no habían aparecido nuevas lesiones, no se reintrodujo el medicamento, estando estable hasta el momento.
La anetodermia es una enfermedad elastolítica benigna que acontece más frecuentemente en mujeres de edad media. Clínicamente se presenta con pápulas y placas bien definidas, eritematosas o normocrómicas, que dejan áreas de piel arrugada, con más o menos atrofia y áreas de herniación blanda1.
Histológicamente se caracteriza por una pérdida focal de fibras elásticas en la dermis reticular y menos frecuentemente en la dermis papilar. Además se suele acompañar de un infiltrado linfohistiocitario, células plasmáticas, células gigantes multinucleadas y excepcionalmente por eosinófilos y neutrófilos2,3.
Se puede distinguir la AP, que aparece en piel clínicamente normal y que puede acompañarse con trastornos autoinmunitarios, de la anetodermia secundaria a distintas dermatosis como el acné, la varicela, los linfomas cutáneos, la sífilis, o el lupus eritematoso cutáneo4,5. Las alteraciones autoinmunes más frecuentes en la AP son la presencia de anticuerpos antifosfolípidos (AAF), con o sin asociación con el síndrome antifosfolípido6, y menos frecuentemente el lupus eritematoso sistémico, la alopecia areata, el vitíligo, el hipotiroidismo4, o alteraciones analíticas como los anticuerpos antinucleares, antitiroideos o hipocomplementemia4,5. De hecho, se ha considerado que la AP constituye un marcador de autoinmunidad, lo que obliga a realizar un exhaustivo estudio de alteraciones inmunes3–6. Recientemente se ha descrito que la elastólisis de la dermis media, otra enfermedad elastolítica, también puede asociarse con la presencia de autoanticuerpos, y específicamente los anticuerpos antifosfolípidos7.
La presencia de AP y síndrome de Sjögren primario es una asociación excepcional, solamente descrita en la literatura en 2 ocasiones4,8, aunque existe un caso de anetodermia secundaria a plasmocitomas múltiples en un paciente con síndrome de Sjögren9. Ninguno de estos casos presentaba además positividad para anticuerpos anticardiolipina.
Existen varias hipótesis sobre la patogenia de la AP. Se ha considerado que se podría producir una isquemia local a través de microtrombosis, vasculitis o por depósitos inmunes (predominantemente IgM y C3) en la pared de los vasos, dando lugar a una degeneración del tejido elástico dérmico3,5. Aunque se desconoce qué papel tendrían los AAF, también se ha propuesto que la presencia de neutrófilos en el infiltrado alteraría la elastina debido a la secreción de elastasas10. Dado que no se ha descrito ningún tratamiento efectivo para la AP, los hallazgos previos sugieren que el tratamiento con fármacos con acción inhibidora de la quimiotaxis de los neutrófilos, como la dapsona o la colchicina, podrían ser de utilidad. Braun et al. describieron estabilización de la enfermedad con colchicina11. Sin embargo, Venencie et al. no observaron mejoría con dapsona1.
En resumen, presentamos el primer caso de AP asociado a síndrome de Sjögren primario y anticuerpos anticardiolipina positivos. Estos autoanticuerpos, aunque a títulos bajos (se consideran valores moderados-altos a partir de >40 MPL/ml), junto con la presencia del síndrome de Sjögren, refuerzan la asociación de la AP con trastornos autoinmunes. Asimismo, queremos destacar la presencia de granulocitos en la anetodermia, siendo este un hecho excepcional que obliga a realizar una tinción para fibras elásticas para confirmar el diagnóstico, y además porque estos pacientes podrían beneficiarse de fármacos como la dapsona o la colchicina.